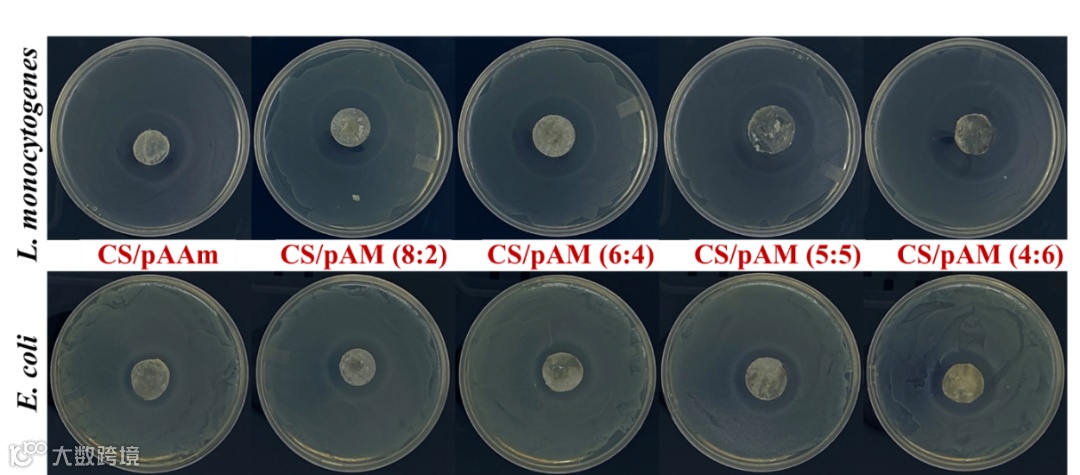

抗菌水凝胶的机械性能差被认为是其在很多应用中的一个障碍。本文通过物理和化学交联成功地制备出一种新型双网络结构的壳聚糖基水凝胶,即壳聚糖/聚丙烯酰胺-[2-(甲基丙烯酰氧基)乙基]三甲基氯化铵水凝胶,其机械性能与聚丙烯酰胺的含量呈正比,抗菌能力与季铵盐化合物的含量也成正比。通过对聚丙烯酰胺和季铵盐化合物的优化,当比例为5:5时,机械力达到530.72 ± 3.19 kPa,对E. coli和L. monocytogenes的抑菌率分别为76.6%(40 mg的冻干样本)和72.85%(20 mg的冻干样本)。本研究中的具有出色的机械性能和抗菌性能的水凝胶,对于各种应用具有潜在的前景。

1.成功制备物理和化学交联的双重网络结构的壳聚糖基水凝胶。
2.聚丙烯酰胺网络给制备的复合水凝胶提供了出色的机械力。
4.季铵盐化合物显著增强了壳聚糖基水凝胶的抗菌能力。
抗菌水凝胶的机械性能差被认为是其在很多应用中的一个障碍。康涅狄格大学Yangchao Luo团队利用物理和化学交联成功地制备出一种新型双网络结构的壳聚糖/聚丙烯酰胺-[2-(甲基丙烯酰氧基)乙基]三甲基氯化铵水凝胶。具体地,通过丙烯酰胺和季铵盐化合物的自由基聚合反应形成一层化学网络,壳聚糖的存在形成一层氢键为主的物理网络。通过调整丙烯酰胺和季铵盐的比例,得到最理想的机械力和抗菌能力。结果显示,当比例为5:5时,机械力达到530.72 ± 3.19 kPa,对E. coli和L. monocytogenes的抑菌率分别为76.6%(40 mg的冻干样本)和72.85%(20 mg的冻干样本)。本研究中的具有出色的机械性能和抗菌性能的水凝胶,对于各种应用具有潜在的前景。
图1a为壳聚糖基双网络(壳聚糖/聚丙烯酰胺-[2-(甲基丙烯酰氧基)乙基]三甲基氯化铵,简写CS/pAM)水凝胶的制备原理。丙烯酰胺,季铵盐化合物和化学交联剂BIS之间的化学网络可以通过引发剂APS促进的自由基聚合来构建。此外,壳聚糖的存在促使丙烯酰胺和壳聚糖本身之间形成氢键,有助于水凝胶内部的物理网络的形成。因此,丙烯酰胺是该复合水凝胶的主要组成部分。图1b展示出丙烯酰胺和季铵盐化合物不同比例所制成的水凝胶。


图1. (a)复合水凝胶的制备原理。(b)制备好的水凝胶图片
图2利用质构仪和流变仪对水凝胶的机械力进行了研究。在质构仪分析中,图a显示,除了CS/pAM(2:8)水凝胶外,各个不同比例的水凝胶都能承受住85%的压力。图b和c则是根据图a,得到的具体的压应力值,对于水凝胶CS/pA,CS/pAM(8:2),CS/pAM(6:4),CS/pAM(5:5)和CS/pAM(4:6),分别为655.44kPa,587.4 kPa,568.99 kPa,530.72 kPa和439.95 kPa。图d显示了水凝胶的粘弹性,所有制备的水凝胶的储存模量G’全部高于损耗模量G’’,证明了弹性响应主导了它们的流变性能,这属于水凝胶的一种特殊性质。

图2. (a)不同复合水凝胶的压缩测试过程展示图。(b)复合水凝胶的应力-应变曲线。(c)从应力-应变曲线计算得出的复合水凝胶在85%应变下的压缩应力。(d)复合水凝胶的动态流变性能。
图3为水凝胶在不同放大倍数下的SEM图。通过图3a-e的分析,所有的水凝胶都具有排列规则的网状结构,孔壁光滑平坦,这种特征形态与双网络水凝胶的典型特征一致。但是丙烯酰胺的减少和MTAC的增加,水凝胶的的网络结构逐渐发生变化,即变得越来越薄。这样的变化导致水凝胶的抗压能力变弱,进一步证明了之前的质构仪结果。

图3. SEM显微照片不同放大倍数下的水凝胶的微观结构:500倍放大(上图)和1000倍放大(下图)。
图4利用13C核磁共振谱、FTIR、XRD等测试对水凝胶的结构、化学组成、结晶度等进行系统表征。在13C核磁共振谱和FTIR光谱中可以观察到MTAC和丙烯酰胺的特征峰,证明了复合水凝胶的成功制备。XRD图谱证明了水凝胶的结晶度随着丙烯酰胺的减少,MTAC的增加而降低,依次为31.25%,31.08%,26.82%,21.97%,和21.4%。这一结果可能是由于壳聚糖中的氨基和羟基之间的氢键发生变形,以及壳聚糖与丙烯酰胺之间形成其他氢键所导致的。

图4. (a-d) 13C核磁共振谱. (e)FTIR光谱图。(f)XRD图谱。
图5为各个水凝胶在去离子水中的溶胀率。CS/pA水凝胶的溶胀率只有12.33g/g,然而随着MTAC的加入,水凝胶的溶胀率显著增加。这是因为MTAC含有正电荷的季铵盐,随着MTAC增加,正电荷也随之增加,导致水凝胶网络内的离子电荷引起的静电斥力增加,最终导致水凝胶的溶胀率提高。但是结果发现,含有CS/pAM(4:6)水凝胶的溶胀率反而降低,这可能的原因是它的机械应力最差,无法支撑过多的水。

图6和表1为各个水凝胶对L. monocytogenes和E. coli的抑菌圈大小结果。从图6可以看出,抑菌圈的大小随着MTAC的增加而显著增加,这是因为MTAC中的季铵盐成分具有很强的抑菌效果。对于L. monocytogenes和E. coli的抑菌圈,最大可达到41.8mm和31.73mm。图7则是两种细菌的抑制率结果。由于两种菌的性质不一样,即革兰氏阳性菌的膜和革兰氏阴性菌菌的膜组成不一样,抑制两种菌所需的水凝胶的量也不一样。对L. monocytogenes菌,20mg的冻干水凝胶样品的抑菌率最高可达82.63%,然而同样的计量对于E. coli,基本没有抑菌效果。当用40mg的冻干水凝胶样品,E. coli抑菌率最高可达82.55%。其中水凝胶CS/paAM(5:5)对于E. coli和L. monocytogenes的抑菌率分别为76.6%(40 mg的冻干样本)和72.85%(20 mg的冻干样本)。

图7. 不同水凝胶对L. monocytogenes和E. coli的抑制率。
原文链接:
Construction and characterization of chitosan/poly(acrylamide‐[2‐(methacryloyloxy)ethyl]trimethylammonium chloride) double‐network hydrogel with enhanced antibacterial activity
Honglin Zhu, Tiangang Yang, Sunni Chen, Xinhao Wang1, Jie He, Yangchao Luo*
Advanced Composites and Hybrid Materials (2023) 6:192
https://doi.org/10.1007/s42114-023-00773-7
作者简介
朱宏林
本文第一作者
康涅狄格大学 博士生
主要研究领域
壳聚糖基水凝胶的制备及其在污水处理中的应用
几丁质的提取及其利用
个人简介
康涅狄格大学营养科学博士生,在《International Journal of Biological Macromolecules》、《Advanced Composites and Hybrid Materials》、《Current Opinion in Food Science》、《Journal of Materials Chemistry B》、《Journal of Agriculture and Food Research》等国际高水平期刊发表SCI论文5篇。
罗阳超
本文通讯作者
美国康涅狄格大学 副教授
主要研究领域
天然高分子材料在营养,食品,以及农业方面的应用。
个人简介
罗阳超博士目前担任美国康涅狄格大学营养系的副教授。2012年获得美国马里大学博士学位,主要研究食品纳米与高分子材料,曾于2012-2013年在美国田纳西大学做博士后研究工作。近十年(2014-2023)期间,发表高水平SCI论文120余篇。目前担任Elsevier旗下International Journal of Biological Macromolecules副总编,Journal of Agriculture and Food Research主编。
高分子科技原创文章。欢迎个人转发和分享,刊物或媒体如需转载,请联系邮箱:info@polymer.cn
欢迎专家学者提供稿件(论文、项目介绍、新技术、学术交流、单位新闻、参会信息、招聘招生等)至info@polymer.cn,并请注明详细联系信息。高分子科技®会及时推送,并同时发布在中国聚合物网上。
欢迎加入微信群 为满足高分子产学研各界同仁的要求,陆续开通了包括高分子专家学者群在内的几十个专项交流群,也包括高分子产业技术、企业家、博士、研究生、媒体期刊会展协会等群,全覆盖高分子产业或领域。目前汇聚了国内外高校科研院所及企业研发中心的上万名顶尖的专家学者、技术人员及企业家。
申请入群,请先加审核微信号PolymerChina(或长按下方二维码),并请一定注明:高分子+姓名+单位+职称(或学位)+领域(或行业),否则不予受理,资格经过审核后入相关专业群。